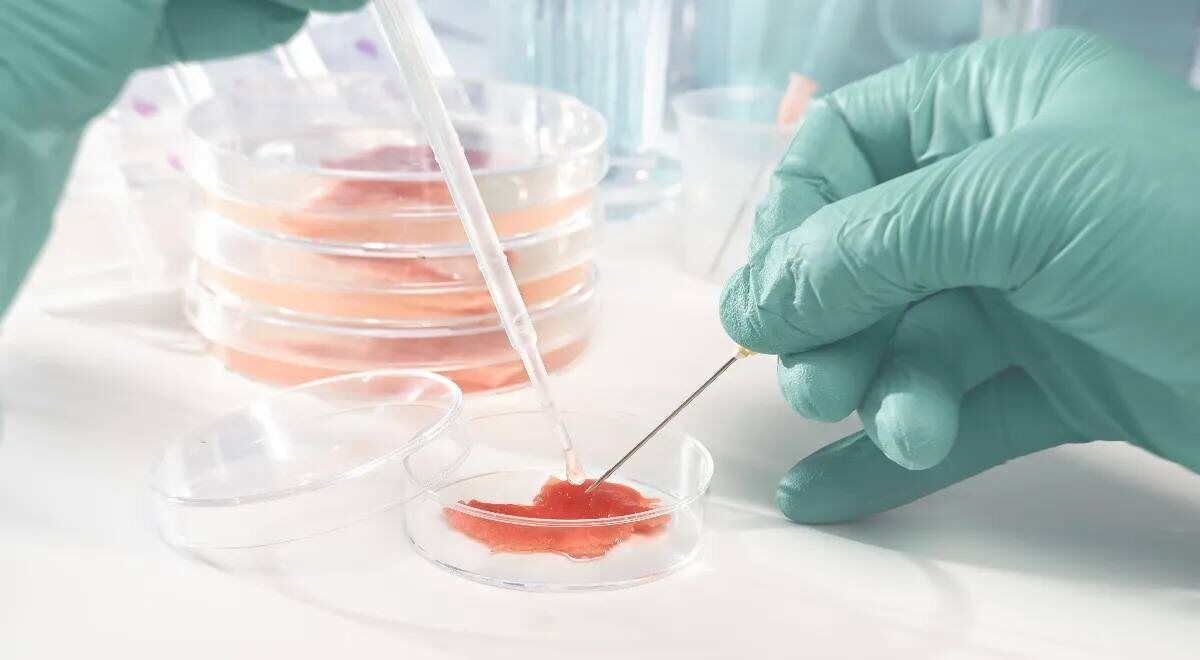
Мясо из пробирки: швейцарские ученые делают это возможным

Продукты, которые кажутся обыденными, могут удивить своим великолепным вкусом и многофункциональностью, если подойти к их приготовлению с любовью и вниманием. Домашняя томатная паста — это больше, чем просто заготовка; это идеальный вариант для тех...
Все новости
В современной кулинарии существует множество рецептов, которые невозможно не полюбить. Одним из таких является простой, но весьма эффектный рецепт лепешек, которые можно приготовить всего за 20 минут. Эти румяные и аппетитные лепешки...
Есть блюда, которые мгновенно привлекают внимание и делают вечер незабываемым. Испанский мясной торт — это нечто особенное: за его внешностью скрывается сочная мясная начинка на ароматной картофельной основе. Если хотите удивить домашних новым...
Каждая хозяйка знакома с проблемой выкипевшей жидкости из кастрюли. Этот неприятный момент не только приводит к необходимости уборки, но и может стать причиной серьёзной опасности на кухне. Как же избежать этой ситуации? В этой статье представлены три...
Швейцарские исследователи произвели настоящую революцию в мире гастрономии, создав мясо в условиях лаборатории. Теперь сочные стейки можно выращивать без использования традиционного животноводства, и их отличия от натуральных продуктов...
Подготовка к посевной кампании — это настоящая наука, где на успех влияет множество факторов. Качество семян и почвы, соблюдение агротехнических норм и, конечно, погодные условия — все это имеет значение. Однако стоит обратить внимание на более тонкие...
Международная команда учёных представила оригинальное биологическое решение для борьбы с комарами: гриб, издающий сладковатый «цветочный» запах и смертельно опасный для насекомых. Исследователи из Университета Мэриленда вместе с коллегами из Китая...
Кулинарное искусство всегда находит новые необычные сочетания. Одно из таких — гармония сладкой клубники и курицы, известная многим гурманам. Данная комбинация может стать основой для множества салатов, причем можно использовать различные ингредиенты:...
Роскачество опубликовало полезные рекомендации для любителей пенного напитка в Туле, объяснив, как закуска способна раскрыть богатство вкуса пива. Правильное сочетание еды и напитка может не просто усилить впечатления, но и создать гармонию во...
Завтрак — это время, когда важна каждая минута. Нужно подать что-то быстрое и сытное, чтобы все успели и не начался утренний хаос. Вот пять оригинальных завтраков, которые можно приготовить в аэрогриле всего за несколько минут...
Слива, плодовое дерево из семейства розовых, продолжает завораживать садоводов своей красотой и неповторимым вкусом. Этот фрукт имеет не только эстетическую ценность, но и играет важную роль в кулинарии и медицине. Сорта сливы...
Когда помидоры достигают потолка теплицы, возникает вопрос: что делать дальше? Лето впереди, и хочется продолжать наслаждаться плодами этого растения. Большинство современных сортов томатов относятся к индетерминантным. Это значит, что они могут расти...
Доцент кафедры неорганической химии имени А.Н. Реформатского РТУ МИРЭА Андрей Дорохов в недавнем интервью отметил важность регулярной дезинфекции мобильных телефонов. Множество людей ежедневно прикладывают смартфоны к лицу, но многие не задумываются о...
Бывают дни, когда хочется похвастаться шикарным десертом, но сил готовить нет? Представляем вам "Ядерную Вафельную Штуку" — идеальный способ поразить друзей в считанные минуты. Этот кулинарный трюк всего за 10 минут позволит избавиться от стресса на...
С наступлением осени садоводы начинают подготовку к следующему сезону, и одним из самых важных этапов является посадка многолетников. Этот период имеет свои преимущества, которые позволяют растениям хорошо укорениться и весной радовать своим...
В последние месяцы медовая вода привлекает внимание все большего числа людей. Данный напиток, как оказывается, не только восхитителен на вкус, но и обладает удивительными свойствами, которые делают его настоящим эликсиром здоровья. В этой статье будет...
Постная выпечка становится все более популярной, открывая новые горизонты в кулинарии. Многие задаются вопросом: как приготовить пирог без яиц, молока и масла, чтобы он не напоминал подошву? Ответ на этот вопрос все более обнадеживает: постная выпечка...
Бриошь — это не просто хлеб, а истинный символ французской выпечки, который сочетает в себе мягкость, легкость и сливочный вкус. Ее неповторимый аромат и текстура делают это лакомство популярным не только во Франции, но и по всему миру. Как же...
Домашнее мороженое — это не только радость для гурманов, но и отличный способ провести время на кухне. Оно готовится легко и из доступных ингредиентов, что делает процесс не только приятным, но и увлекательным. Более того, можно адаптировать рецепты...
Фрикадельки в грибном соусе — это настоящее кулинарное открытие! Сочные, ароматные, эти маленькие угощения просто тают во рту. Если вы ещё не пробовали этот удивительный рецепт, самое время исправить это...